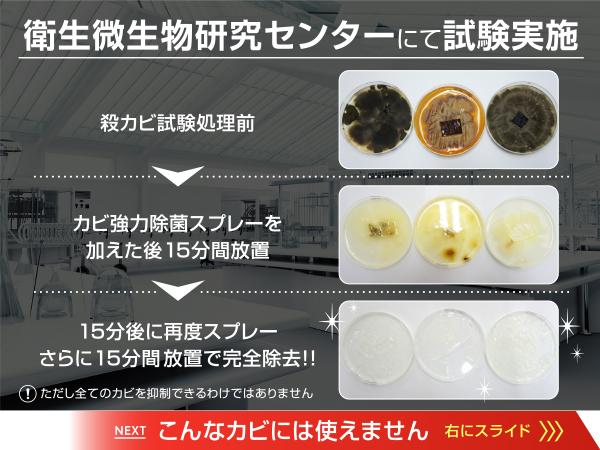

カビホワイトカビ強力除去スプレーカビ取り剤[お風呂・お部屋の壁紙・土壁・タイル] 450ml
(126件)
メーカー希望小売価格: 1,831円
1,831円(税込)
0ポイント(1%)
商品説明
| 商品詳細 | |
| 内容 | カビ強力除去スプレー 450ml |
| 用途 | ビニール素材の壁紙 FRP(強化プラスチック) コンクリート 砂壁 珪藻土などのカビ取り ※砂壁・珪藻土壁などは色落ちしやすい材料が混じっている場合は脱色の恐れがあるため使用不可。 ※古いホーロー・劣化しているホーローは変色の可能性があるため使用不可。 |
| 成分 | 次亜塩素酸ナトリウム 水酸化ナトリウム 界面活性剤 ※独自の配合により、カビが良く取れ、無害なレベルにまでしか対象物に薬剤が残留しない |
| 使用量目安 | カビがひどい場合は、1平方メートルあたり、万遍なく20〜30回のスプレー(20〜30ml程度)を目安に噴霧してください。1本で、約15平方メートルに、万遍なく1回だけスプレーできます。 |
| 使用期限 | 2年間 |
| こちらもおすすめ | カビ取り剤のシリーズ一覧はこちら |

|

|

|

|
|

|

|

|

|

|

|

|

|

|

|

|

|

|

|

|

|
<商品の詳細>
・お風呂(タイル ユニットバス)、壁紙(ビニールクロス)、土壁、珪藻土などのカビ取り剤です。最大12倍まで希釈でき木材や畳や布団のカビ取りも可能です。カビ取り後は乾燥すると成分が蒸発します。
・おそうじ関連業務30年以上、ネット通販15年以上が開発した本格派のカビ取り剤になります。黒カビ 青カビ 赤カビ 緑カビ 白カビを強力除去(衛生微生物研究所調べ)。
・目に見えないカビの菌糸や薬品に耐性を持った塩素耐性菌まで除去するため、次のカビが生えづらく最長3か月程度の防カビが期待できます。
・1本で最大20畳程度にスプレーすることができます。超頑固なカビには原液で、軽度なカビなら最大12倍まで希釈できるので経済的です。
・お掃除例 ユニットバスやタイル貼りのお風呂(天井 壁 床)、リビングやクローゼットやトイレの壁紙(ビニール素材)、土壁、砂壁。希釈した場合は木材、畳、布団、マットレス、ベッドフレームなど。
・お風呂(タイル ユニットバス)、壁紙(ビニールクロス)、土壁、珪藻土などのカビ取り剤です。最大12倍まで希釈でき木材や畳や布団のカビ取りも可能です。カビ取り後は乾燥すると成分が蒸発します。
・おそうじ関連業務30年以上、ネット通販15年以上が開発した本格派のカビ取り剤になります。黒カビ 青カビ 赤カビ 緑カビ 白カビを強力除去(衛生微生物研究所調べ)。
・目に見えないカビの菌糸や薬品に耐性を持った塩素耐性菌まで除去するため、次のカビが生えづらく最長3か月程度の防カビが期待できます。
・1本で最大20畳程度にスプレーすることができます。超頑固なカビには原液で、軽度なカビなら最大12倍まで希釈できるので経済的です。
・お掃除例 ユニットバスやタイル貼りのお風呂(天井 壁 床)、リビングやクローゼットやトイレの壁紙(ビニール素材)、土壁、砂壁。希釈した場合は木材、畳、布団、マットレス、ベッドフレームなど。
カビホワイト とは?
<洗い流しできない箇所にも使用可能>
普通のカビ取り剤はどれも洗い流しが必要なため室内の壁紙や天井には使えませんでしたが、カビホワイト強力除去スプレーは、薬剤が揮発するため、土壁や砂壁などの洗い流しや水拭きができない箇所にもご使用頂けます。
砂壁などの水拭きができない材質は、水道水で2倍に希釈してご使用ください。
1平方メートルあたり15ml 以上使用した場合は、薬剤が残留する可能性がありますので洗い流しや水拭きをしてください。
レビュー
- 3回目です
- 簡単に使えて便利です。冬の終わり頃にいつも使っており本当に良い商品です。
- 壁のカビ対策
- 家族の引越しにあたり、北側のカビが気になり購入しました。まだ使用していませんが期待を込めて。綺麗になると嬉しいな。早い発送ありがとうございました
- とっても良いでございます
- はやい発送ありがとうございます おかげさまでキレイになりました。どうもありがとうございました
- リピート3本目
- 洗い流さなくて良いところがとても便利です。部屋の壁に使えるところが気に入って、リピートしています。
- 感激です
- 半信半疑でしたが、少しでも綺麗になればイイと思って買ったら、真っ黒だった壁が本当に綺麗になりました
すべてのレビューを見る









